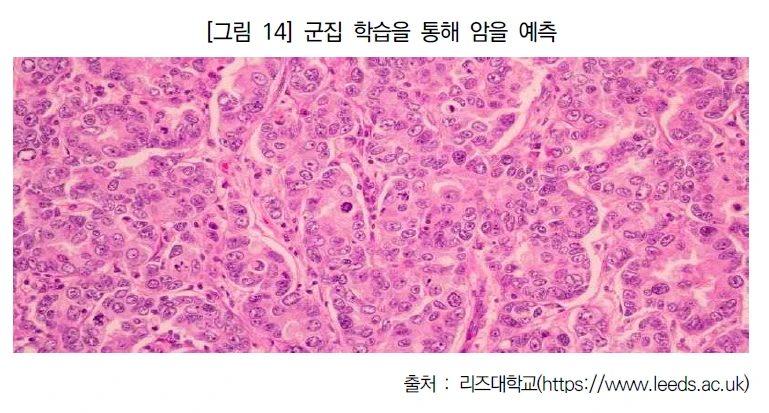

인공지능 이야기 01 -인공지능 활용사례
by
Oct 13. 2022
NIA 에서 발행한 각 나라의 인공지능 활용사례를 정리한 내용을 그래도 옮긴 내용입니다.
출처 : 「한국지능정보사회 진흥원(NIA)」
1.인공지능 적용의 보편화
1) 2021년 세계 인공지능(AI) 시장규모는 400조 원에 달하고, 2024년에는 585조 원으로 증가할 것으로 예상되며, 국내 AI 시장은 2025년까지 1조 9,047 억 원 규모로 성장을 전망한다.(IDC , 2021)

2) 산업 전반의 디지털 전환이 가속화되면서 의료, 제조, 환경, 에너지, 교육, 교통, 행정 등 다양한 분야에서 인공지능을 접목한 서비스가 활용, 확산되기 시작했다.
3) 이미 로봇청소기, AI 스피커, 내비게이션, 가상쇼핑, 교육 서비스, 금융 서비스 등 AI 를 적용한 제품과 서비스는 시장에 출시되어 빠른 속도로 대중화되고 있으며 의료영상판독, 스포츠 판정, 법률 서비스등 전문 서비스 영역에서도 AI 가 적용되는 추세이다.
4)특히, AI 는 '효율성' 측면의 경제적 효율을 넘어, '공공성' 측면에서 사람들의 삶을 변화시키고 다양한 사회문제를 해결하는 공익 실현의 도구로서 가치가 증대되고 있음
2.서비스를 넘어 기술 혁신 도구로서의 AI
1) AI 는 서비스뿐만 아니라 로봇, 드론, 전자현미경, 배터리, 드론 등 다양한 제품의 성능을 개선하거나 기존 기술을 혁신하는 도구로서 활용되고 있음
2)해외 주요국을 중심으로 심층 해양 탐사, 암 연구, 화학반응 예측, 가상 모델 예측력 향상, 질병의 생물할적 언어 이해등 기존 연구의 한계를 극복하는 도구로서 AI 를 활용하기 위한 다양한 연구가 진행 중이다.
3)해외에서 적용한 인공지능(AI) 20개 사례를 보면서 자기의 일상, 회사 업무 어느곳에 적용할지 생각해보면 좋겠다.
4)경영자들은 하루속히 인공지능(AI) 적용하서 결과 보기를 간절히 원하고 있다. 이것을 개발자들이 어느 정도 결과를 보여줘야 하기에 자기 회사내에서 어느 곳에 적용을 해서 보여줘야 할지 판단하면 좋다.
3.각국의 적용사례 20개
1)미국 - 자율 주행 로봇을 통한 심층 해양 탐사
* 미국 우즈홀 해양연구소(Woods Hole Oceanographic Institution)는 해양 종 이동에 초점을 맞추는 컴퓨터
비전 알고리즘을 개발하고, 차량을 조종하는 차량 제어 알고리즘 개발
* 종과 이미지를 식별하는 AI 학습을 통해 느리게 움직이는 해양 생물을 자율적으로 추적·기록하고, 민감한
해양 생물에 혼란을 주지 않으면서 탐사가 가능한 해저 자율주행 로봇 ‘메소봇(Mesobot)’을 제작
* 중층 해역에 서식하는 해양 생물 상당수는 아주 미세한 수준의 움직임에도 극도로 민감하기 때문에 저속
제트를 생성하며 천천히 움직이는 대형 프로펠러 추진 시스템 장착
* 관찰할 생명체에 백색광을 쏘지 않고, 해양 생물이 인지하지 못하는 적샘 빔을 이용하여 생명체 관찰


* 기대효과
- 생물종을 식별하고 추적하는 AI를 개발함으로써 자율적인 수중 연구로봇 개발에서 중대한 장애물을 극복
- 자율 수중로봇을 통해 이전에는 불가능했을 해양 생물 탐사가 가능
* 국내 적용해볼 수 있는 것
- 깊은 바다의 특정생물에 대한 생태계를 파악하는데 사용
2) 미국 -에어로졸이 폭풍에 미치는 영향 분석
*에어로졸이란?
공기 중에 떠 있는 고체 또는 액체 상태의 작은 입자로 보통 0.001∼100μm 정도의 크기를 가지며, 기후변화와 인간 건강과 직접적으로 영향을 주는 물질이다. 에어로졸이 가시광선, 근적외선 등 빛을 얼마나 반사하고 흡수하는지 나타낸 물리량이 에어로졸 광학깊이이다.
* 주요 내용
- "자기 조직화 지도(Self-Organizing Map)"로 알려진 머신러닝 프로그램을 통해 TRACER 이전 10년 간의 기상 관측 데이터를 결합·분석하여 날씨 패턴의 특성에 따라 세 가지 주요 범주로 분류함으로써 폭풍 구름과 강수 특성이 에어로졸 조건에 따라 달라지는 것을 관찰
- 지도에 추가 위성, 레이더 및 지표 기반 관측을 중첩하여 다양한 영역에서 구름의 특성과 강수 특성을 조사
- 결합된 데이터는 압력, 온도, 습도 및 바람을 포함한 3차원 대기 특성 정보를 제공

*기대효과
- 에어로졸이 뇌우의 심각성에 어떻게 영향을 미치는지 이해의 폭을 넓힘
- 대규모 기상 패턴을 추적하여 에어로졸 입자가 폭풍 심각도에 미치는 영향을 풀기 위한 기준 범주를 제공
- 에어로졸 산업 및 천연 소스의 다양한 영향을 예측 가능
- 향후 고해상도 기상 모델링을 사용하여 추가 지역 규모 기상 측정(예: 바닷바람 순환)과 에어로졸 입자의
수, 크기 및 구성에 대한 자세한 정보를 통합 예정
*내 삶에 적용할 수 있는 분야
- 자동차 매연이 기후에 미치는 영향 조사
- 생산 패턴을 분석해서 어느 것을 미리 생산해놓을지를 결정함
- 태풍 방향, 강도에 따라서 강수량을 미리 예측해서 주변 위험 요소를 파악해 인명 피해를 줄이는 역할
3) 미국 - 암 영상 검사를 위한 AI 연구
* 미국 국립암연구소(NCI, National Cancer Institute)는 암을 조기발견하고, 암 증상이 있는 사람들의 암 검출을 개선하고, 암 치료법을 선택할 수 있는 AI 도구 개발
* (암 조기발견) 암 이미징 응용 프로그램에서 딥러닝을 사용하여 현재 도구보다 더 정확하게 햐우 5년 동안 유방암 발병 위험을 예측하고 훈련된 전문가보다 더 우수하게 자궁경부전암을 검사
* (암의 검출) 방사선과 의사들이 다중 매개변수 MRI라고 하는 비교적 새로운 종류의 전립선 MRI 스캔
으로 전립선암을 더 쉽게 발견할 수 있는 AI 모델 개발

*(암 치료법 선택) 방광암 환자의 단발성 종양 조직 이미지를 보고 인근 림프절에 미세한 암 클러스터가
있는지 여부를 예측함으로써 수술 외에 다른 치료가 필요할 가능성을 결정할 수 있는 딥러닝 모델 개발

* 기대효과
현재 인간이 수행할 수 있으나 장시간 소요되는 평가 및 작업을 자동화
- 의사는 AI가 수행한 분석 결과의 검토만 수행하므로 시간과 비용이 획기적으로 절약
- 의사의 암 영상 진단 이후 환자의 다양한 질문에 대한 답변 속도 및 정확성 향상
- 경험이 부족한 의사의 암 진단 결정 과정에 도움
4. 납세자를 위한 음성 봇 및 챗봇(미국)
* 현황 및 문제점
미국 국세청(IRS, Internal Revenue Service)은 납세 관련 상담 전화가 전례 없이 폭주함에 따라 통화
연결이 어려워 납세자가 긴 시간 동안 대기함에 따른 불편 초래
* 상담을 위한 음성 봇 및 챗봇 배포
(음성 봇) AI 기반 대화형 질의응답 소프트웨어로 발신자가 음성으로 질의하면 음성으로 답변
(챗봇) 웹 기반 텍스트 상호작용을 통해 인간 대화를 시뮬레이션하고, AI 기반 소프트웨어를 사용하여 자연어 메시지에 응답
5. AI를 이용한 화학반응 예측(미국)
* 미국 아이다호 국립연구소(Idaho National Laboratory)는 머신러닝을 통해 화학반응을 예측하는 프로
그램을 개발함으로써 화학반응 시간을 단축하고, 화학반응에 대한 설명력을 제고

* 기대효과
- 머신러닝을 통한 수학적 모델을 디지털 트윈이라고 하는 컴퓨터 시뮬레이션에 적용하기 위해 조지아 공과
대학과 협력 중이며 향후 시뮬레이션을 통해 과학자들은 반응의 한 측면을 변경하면 어떤 일이 일어날
지 정확한 예측도 가능
- 시뮬레이션을 통해 결과가 나쁘거나 안전하지 않은 상태로 이어질 수 있는 상황을 예측하여 회피할 수
있으며, 수천 가지 조건을 테스트함으로써 시간과 비용을 절약할 수 있음
6. 딥러닝 기반 해양 야생생물 항공 조사(미국)
* 대서양 연안과 외곽 대륙붕을 가로질러 에너지 개발이 증가함에 따라 연안 에너지 활동에 영향을 받을
수 있는 바다새, 해양 포유류 및 바다거북을 포함한 해양 생물종의 계절별 분포 정보 필요
( 구축된 데이터베이스는 딥러닝 컴퓨터 비전 알고리즘을 훈련하고, 훈련된 딥러닝 모델은 새로운 이미지
에서 종을 자동으로 감지하고 계산(87% 정확도) 함으로써 종 탐지 정확도 향상

7. AI를 이용한 비행기 제조과정 개선(미국)
* 항공기 부품 수는 자동차의 10배인 20만 개 수준으로 비행기 부품 제조는 매우 복잡하고, 정교하며 값
비싼 기계가 포함될 뿐만 아니라 다양한 조건을 시뮬레이션 함에 따라 오랜 시간이 소요
* 새로운 머신러닝 접근 방식으로 값비싼 실험과 많은 시간이 소모되는 시뮬레이션의 수를 줄임으로써 훨씬 짧은 시간과 적은 비용으로 제조 프로세스에 대한 귀중한 정보를 제공하는 정확한 모델을 생성
8. AI로 전자현미경 성능 향상(미국)
* 미국 에너지부(DOE) 아르곤 국립연구소(Argonne National Laboratory)는 AI의 한 형태인 심층 신경망을 활용하여 이미징 기술을 개선
- AI 프레임워크를 독특한 방식으로 사용하여 전자현미경의 해상도와 감도를 향상시키는 방법을 발견
* 위상 정보 검색 문제해결을 위해 심층 신경망을 훈련하기 위해 구축된 도구 활용을 제안
- Google 및 Facebook 등의 신경망 훈련 소프트웨어 패키지를 활용하여 위상 정복 복구 방법 시연

9. 차세대 전력망 비상 제어 기술(미국)
* 현황 및 문제점
- 미국의 정전 건수 증가에 따라 정전으로 인한 피해액이 매년 300~500억 달러에 육박
- 전력 서비스가 중단되는 등의 비상 상황을 최소화하기 위해 전력 시스템 응답 최적화 필요
* 심층 강화학습이라는 AI 유형을 사용하여 장애 발생 몇 초 이내에 의사 결정 및 시스템 응답을 자동화

10. AI 기반 전투관리 훈련(미국)
* BMTN은 지휘 및 통제 전투 관리 요원에게 지속적이고 고품질의 저비용 훈련을 반복 제공
- 머신러닝, 생체 인식 및 자연어 처리 기능을 하나의 명령 및 제어 교육 시스템에 통합함으로써 AI 튜터를
통해 핵심 및 고급 기술을 교육하고 훈련생의 요구와 기술에 따라 시나리오 조정

11. AI로 허리케인 모델 예측력 향상(미국)
* 현황 및 문제점
- 현재 기상학자들은 허리케인 궤도는 비교적 잘 예측하는 반면 허리케인의 세력이 언제 강해질지는 기존
최고의 모델로도 예측하기 어려워 피해 예방에 한계
- 미국 국립해양대기청(National Oceanic and Atmospheric Administration)은 지구 온난화에 따라
더 따뜻해지는 미래에는 허리케인 강도가 평균 1~10% 증가하여 더 큰 파괴력을 가져올 것이라고 예측
* 주요 내용
- 미국 퍼시픽 노스웨스트 국립연구소(Pacific Northwest National Laboratory)는 일반 노트북에서도
사용할 수 있고 기존 모델에 비해 강도 예측 오차를 22% 줄인 딥러닝 기반 허리케인 예측 모델 개발
* 기대효과
- 극단적인 기상 현상이 더 빈번함에 따라 허리케인이 지구온난화 상에서 어떻게 행동할지에 대한 이해를
돕고, 조기 허리케인 예측에 따른 피해 최소화
12. AI 기반 로봇 터치 감지 개선(독일)
* 독일 막스 플랑크 지능시스템 연구소(Max Planck Institute for Intelligent Systems)는 터치 감지를
개선하기 위해 카메라가 내부에 숨겨져 있는 엄지 모양의 센서를 개발
https://www.youtube.com/watch?v=lTAJwcZopAA
* 센서를 통한 접촉 정보를 추론하도록 심층 신경망 훈련으로 로봇 손가락의 햅틱 인식을 개선
- 무언가가 손가락에 닿으면 시스템은 유연한 외부 쉘의 가시적 변형으로부터 3차원 포스 맵을 구성
- 로봇 손가락의 햅틱 인식을 크게 향상시켜 인간의 피부에 닿는 감각에 더욱 가까워짐.
- 혁신적인 기계 설계, 내부 맞춤형 이미징 시스템, 자동 데이터 수집 및 최첨단 딥러닝을 통해 매우 민감
하고, 견고하며, 고해상도 인식이 가능한 감지 성능을 달성
* 기대효과
- AI를 이용해 로봇의 물체 감지 성능을 획기적으로 개선할 수 있으며 다양한 모양과 정밀도 요구 사항을
가진 로봇 본체 부품에 적용 및 확장 가능

13. 감정적 상호작용을 위한 안드로이드(일본)
* 주요 내용
일본 이화학연구소(RIKEN) 가디언로봇 프로젝트팀은 행복, 놀라움, 슬픔, 두려움, 분노, 혐오 등 6가지
감정을 전달할 수 있는 소년 안드로이드 ‘니콜라(Nikola)’ 개발
(안드로이드 : 사람을 닮은 로봇)
* 니콜라의 얼굴 내부에는 인공 근육의 움직임을 제어하는 29개의 공압 액추에이터가 있으며, 표정 연구에
광범위하게 사용되는 FACS(Facial Action Coding System)를 기반으로 액추에이터를 배치

https://www.youtube.com/watch?v=U9r4KbFKScI
14. AI를 사용하여 환자 데이터에서 암을 안전하게 검출(영국)
* 영국 리즈대학 연구팀은 AI의 한 형태인 군집 학습을 통해 데이터를 공개하지 않고 환자 조직 샘플의
의료 이미지에서 암을 예측하는 AI 모델을 개발

15. AI를 도입하여 철도 건널목 안전성 향상(스위스)
*철도 건널목 안전을 개선하기 위해 AI 비디오 분석 솔루션 ‘Scene Analytics’를 스위스 뮌헨슈타인에서 운영 중인 트램 BTL(Baselland Transport AG)에 우선 도입
* 머신러닝 및 컴퓨터 비전 기능을 결합하여 철도 건널목 관련 중요 정보를 실시간 제공함으로써 철도 건
널목 사고 예방 및 피해 최소화

16. 작곡에 영감을 주는 실시간 가사 시스템(캐나다)
* 캐나다 워털루대학교 자연어처리연구소(Natural Language Processing Lab)는 라이브 음악으로 표현
되는 분위기와 감정을 반영하여 AI로 가사 라인을 생성하는 실시간 시스템 ‘LyricJam’ 개발

17. 질병 조기발견 및 치료를 위한 이식형 AI 시스템(독일)
* 독일 드레스덴 대학 연구팀은 심장 박동과 같은 생물학적 신호에서 실시간으로 건강 및 병리학적 패턴을
분류함으로써 의료 감독 없이도 병리학적 변화를 감지할 수 있는 생체 적합성 이식형 AI 플랫폼 개발
* 수술 후 심장 부정맥이나 합병증의 모니터링, 스마트폰을 통해 의사 및 환자에게 환자상태 보고 등 이식
가능한 AI 시스템의 잠재적인 응용 분야는 다양

18. 머신러닝 이용해 질병의 생물학적 언어 예측(영국)
* 영국 세인트존스 칼리지 연구진은 신경망 기반 언어 모델에 단백질 언어를 학습시키고 예측할 수 있도록
함으로써 신체 내부 단백질 문제 발생에 따른 질병 유발을 예측
* 머신러닝 기술이 신체 내부의 단백질에 문제가 발생하여 질병을 유발할 때 어떤 일이 일어나는지 살펴
보기 위해 신경망 기반 언어 모델에 단백질 언어를 학습
* 세포에서 발견되는 단백질 응축물에 대해 컴퓨터 학습시킨 결과 알고리즘은 직접 설명을 듣지 않고도 세포안에서 어떤 단백질이 응축물을 형성하는지 알아내는 방법을 익힘

19. 저에너지 AI를 제공할 수 있는 나노마그네틱 컴퓨팅(영국)
* 영국 임페리얼 칼리지 런던 연구팀은 나노 자석의 네트워크를 사용해 AI와 유사한 처리를 할 수 있는
방법을 실증함으로써 잠재적으로 엄청난 에너지를 절약
- 연구팀은 자기장이 통과한 후 각 상태에서 자석의 수를 세어 '답'을 제공하는 기술을 설계
- 나노자석 네트워크가 AI와 유사한 처리를 수행하는 데 사용될 수 있다는 증거를 제시
- 연구팀은 자석을 사용하여 데이터를 처리하고 저장할 수 있게 하고, 소프트웨어 시뮬레이션의 중개자를
제거함으로써 잠재적으로 엄청난 에너지를 절약

20. 꽃 모양 학습을 통한 드론 비행 기술 향상(네덜란드)
* 네덜란드 델프트 공과대학교 연구팀은 드론이 꽃, 잔디 등 물체의 시각적 외관(모양, 색상, 질감)을 통해
거리를 추정할 수 있도록 광학 흐름 기반 학습 프로세스 제시
- 드론이 거리를 보는 법을 학습하기 위해 광학 흐름 진동을 사용
* 시각적 외관을 통해 거리를 보는 방법을 AI를 통해 학습함으로써 소형 비행 드론의 탐색 기술을 향상
- 이전보다 훨씬 빠르고 부드러운 착륙이 가능하며, 장애물 감지 성능 및 속도 향상뿐만 아니라 온실과
같이 실내에서 작물을 모니터링 하거나 창고의 재고를 추적하는 등 제한된 환경에서 비행 시 유용